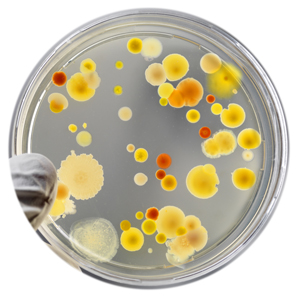
Bacteria

Sherlock CAS Overview
Sherlock CAS Overview Flyer Sherlock CAS: Specification Sheet Sherlock CAS: Site Preparation Sheet 
Soil Microbial Community (PLFA) Analysis
Rapid PLFA Analysis on a GC-2010/2030 Automated PLFA Analysis Tools USDA-ARS: Rapid Soil Extraction Procedure
Microbial Identification
Automated Microbial ID on a GC-2010/2030 
Marine Oil and Omega-3 Analysis
Automated Fish Oil Fatty Acid AnalysisMIDI Now Adds Shimadzu Instrument Support in the USA and Select Countries
In 2017, Shimadzu Scientific Instruments (SSI) and MIDI, Inc. formed a strategic partnership to develop and market automated chromatographic solutions for agri-biotech, biodefense, dietary supplement, food science,
forensics and renewable energy laboratories. These automated testing solutions will save analysis time, reduce labor costs, while providing unprecedented analytical accuracy over the "manual" chromatography approaches used in these industries.
Several of these solutions are now available for Shimadzu Corporation's GC-2010/2030 hardware and LabSolutions™ software. This request form is to receive additional information about MIDI's new Sherlock applications on Shimadzu's GC hardware only.
MIDI Contact Info
by email to:
by phone to: 1-302-737-4297
by fax to: 1-302-737-7781
Please fill out the following form to request more information.
